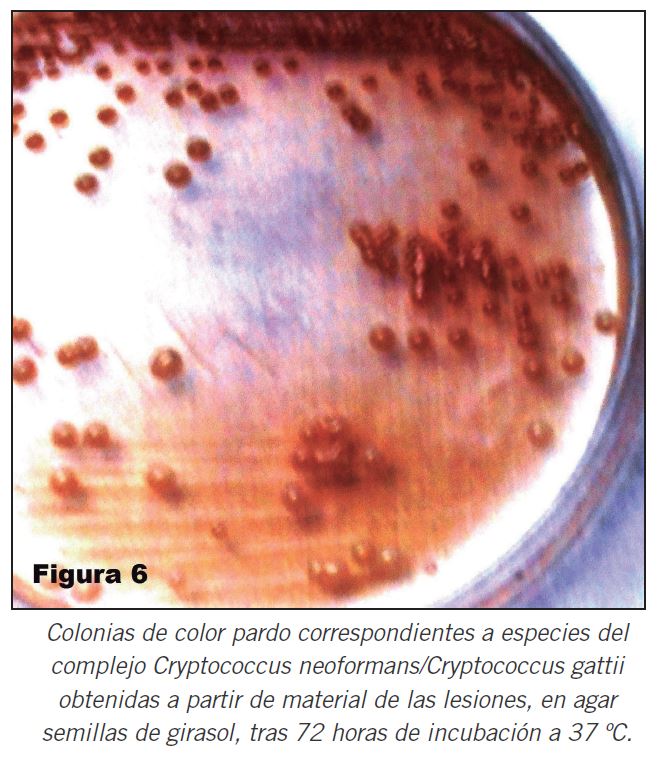

BIOQUÍMICA EN IMÁGENES
La microscopia del material obtenido por escarificación de lesiones cutáneas constituye un método rápido (respecto del estudio histopatológico de las biopsias) y sencillo para el diagnóstico de las micosis sistémicas. La aplicación de coloraciones a las preparaciones microscópicas previamente fijadas permiten la identificación de elementos fúngicos de importancia diagnóstica.

Notas de autor
1 Especialista en Bioquímica Clínica y Parasitología
2 Doctor en Medicina
amadeojavier.1954@gmail.com
